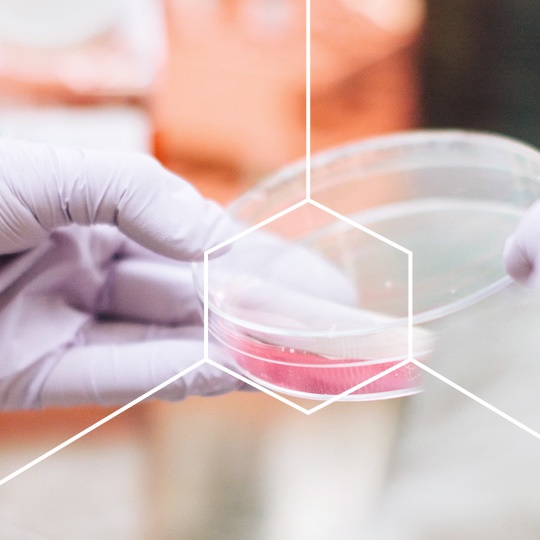

Mikroalgi spiruliny to znane superfood, które łatwo ulegają rozkładowi w jelitach. Sprawia to, że jej składniki są optymalnie absorbowane przez organizm. W przeciwieństwie do spermidyny pozyskiwanej z kiełków pszenicy, spermidyna w MitoSpermidin® pozbawiona jest alergenów, a preparat jest produktem bezglutenowym. Ponadto spirulina jest pozyskiwana z jezior sodowych, a nie z mórz, dzięki czemu ma niską zawartość jodu, a zatem jest dobrze tolerowana przez osoby z nietolerancją pokarmową jodu.
Autofagia to proces, w którym komórki organizmu rozkładają uszkodzone lub zużyte składniki, a następnie zamieniają je na energię. Ich usuwanie wspomaga metabolizm komórkowy, utrzymując je dłużej w zdrowiu. Autofagię w komórce można stymulować przez post, ćwiczenia i spożywanie produktów, takich jak kiełki pszenicy czy mikroalgi. Dlatego preparat MitoSpermidin® skutecznie łączy się z okresowym postem lub może naśladować jego działanie.
MitoSpermidin® zawiera dodatkowo w zalecanej dziennej porcji: 10 mg cynku oraz 2000 IU witaminy D celem zachowania zdrowego układu odpornościowego.
na prosty zwrot towaru
certyfikat SSL
płatności on-line
Kiedy warto stosować MitoSpermidin®?
- Gdy chcesz wspomóc prawidłowe funkcjonowanie układu odpornościowego (witamina D, cynk).
- Jeśli zależy Ci na utrzymaniu właściwych funkcji poznawczych, na prawidłowej syntezie DNA oraz na ochronie komórek przed stresem oksydacyjnym (cynk).
- Witamina D i cynk odgrywają również ważne role w procesie podziału komórek.
- Kiedy Twój organizm wykazuje zwiększone zapotrzebowanie na zawarte w preparacie składniki czynne.

Dlaczego spermidyna MitoSpermidin®?
- MitoSpermidin® to naturalny preparat roślinny, na bazie mikroalg Spirulina platensis, który dostarcza 0,3 mg spermidyny w jednej kapsułce. Preparat został wzbogacony o witaminę D w porcji 25 µg (1000 I.U.) oraz cynk w porcji 5 mg.
- Spirulina nie posiada ścian komórkowych zawierających celulozę i dlatego jest lekkostrawna. Ponieważ jest pozyskiwana z jezior sodowych, a nie z mórz, ma niską zawartość jodu, a zatem jest dobrze tolerowana przez osoby uczulone na jod.
- Spirulina platensis jest również naturalnym źródłem spermidyny.
- Cynk zawarty w MitoSpermidin® ma postać diglicynianu cynku, który wykazuje lepszą wchłanialność w porównaniu do innych jego form.
- MitoSpermidin® jest dobrze tolerowany. To produkt bezglutenowy, niezawierający białka mleka krowiego, laktozy, soi, drożdży, żelatyny, aromatów, barwników i substancji konserwujących. Jest odpowiedni dla wegan, wegetarian oraz osób nietolerujących wyżej wymienionych składników.
MitoSpermidin® - jak stosować?
- 2 kapsułki dziennie, do posiłku.
- Nie zapomnij popić odpowiednią ilością wody.

Czym jest spermidyna?
- Spermidyna to poliamina, która jest naturalnie wytwarzana przez organizm i może być wchłaniana z pożywieniem. Bierze udział w tworzeniu sperminy z putrescyny i S-adenozylometioniny.
- Komórki naszego ciała wytwarzają około jednej trzeciej ilości spermidyny obecnej w naszym organizmie. Jednak wraz z wiekiem ilość spermidyny w komórkach organizmu maleje.
- W naszej diecie występuje w pokarmach takich, jak kiełki i pączki kiełków pszenicy, spirulina, rośliny strączkowe, soja i produkty pełnoziarniste, orzechy czy sery dojrzewające.

Właściwości spermidyny
- Mimo że nasze ciało samo wytwarza spermidynę, jej endogenna produkcja znacząco spada z wiekiem. Oznacza to, że nasze komórki mają wtedy mniej spermidyny aktywizującej autofagię.
- Komórki naszego organizmu mają zdolność do odnowy, która zachodzi m.in. w procesie autofagii. Jest to istotny mechanizm, dzięki któremu komórki ciała pozostają zdrowe i funkcjonują prawidłowo. Powyższy materiał został przygotowany na podstawie badań/ źródeł naukowych.
Nie stanowi zaleceń lekarskich bądź dietetycznych i ma charakter wyłącznie informacyjny.

Jakość i czystość preparatu MitoSpermidin®?
- Wszystkie preparaty oferowane przez firmę Mito-Pharma® produkowane są w Niemczech, w oparciu o 50 lat badań i praktyki dr. Franza Enzmanna z zachowaniem najwyższych standardów jakości GMP (zasada dobrej praktyki produkcyjnej). GMP gwarantuje ścisłą kontrolę od momentu zaopatrzenia w surowce, poprzez produkcję, pakowanie, aż do składowania i dystrybucji preparatu. Dzięki temu eliminowane są wszelkie zagrożenia dotyczące zanieczyszczenia preparatu obcymi substancjami chemicznymi, czy też szkodliwą mikroflorą.
- Preparat zawiera fizjologiczne substancje o możliwie najwyższym stopniu czystości w odpowiednio wysokich porcjach i formie.

Suplement diety
MitoSpermidin® zawiera bogatą w spermidynę mikroalgę spirulina platensis, z dodatkiem cynku i witaminy D.
Przed zastosowaniem wskazane jest wykonanie badania 25-(OH)D we krwi oraz konsultacja wyniku badania z lekarzem lub farmaceutą.
Zawartość opakowania:
90 kapsułek – 66,3 g
1 kapsułka – 737 mg
Składniki:
spirulina platensis, roślinne kapsułki z hydroksypropylometylocelulozy, maltodekstryna, wypełniacz z celulozy mikrokrystalicznej, diglicynian cynku, substancje przeciwzbrylające: sole magnezowe kwasów tłuszczowych i dwutlenek krzemu, cholekalcyferol.
Zalecana porcja dzienna: 2 kapsułki dziennie podczas posiłku, popijając wystarczającą ilością płynu.
Skład zalecanej dziennej porcji:
Substancja | 2 kapsułki | *RWS |
---|---|---|
Spirulina platensis, w tym: Spermidyna | 926 mg 0,6 mg | - |
Cynk | 10 mg | 100% |
Witamina D | 50 µg (2.000 IU**) | 1.000% |
* RWS - Referencyjna Wartość Spożycia
** I.U. jednostki międzynarodowe
Nie należy przekraczać zalecanej dziennej porcji do spożycia. Suplement diety nie może być stosowany jako substytut (zamiennik) zróżnicowanej diety. Należy przestrzegać zdrowego trybu życia i zrównoważonego sposobu żywienia. Nie stosować w przypadku nadwrażliwości na składniki preparatu. Produkt nie jest przeznaczony dla kobiet w ciąży ani karmiących piersią. Przed zastosowaniem wskazane jest wykonanie badania 25-(OH)D we krwi oraz konsultacja wyniku badania z lekarzem lub farmaceutą.
Warunki przechowywania:
Przechowywać poza zasięgiem małych dzieci, zamknięte, w temperaturze pokojowej, w suchym miejscu.
Najlepiej spożyć przed końcem (miesiąc, rok) / Numer partii: patrz etykieta na spodzie.
Wyprodukowano przez: MSE Pharmazeutika GmbH, Dr. Franz Enzmann, Nehringstrasse 15, D-61352 Bad Homburg (NIEMCY)
Dla: Mito-Pharma Sp. z o.o., ul. gen. Władysława Sikorskiego 22, 66-400 Gorzów Wielkopolski (POLSKA), tel.: 095 736 50 50, email: biuro@mito-pharma.pl / www.mito-pharma.pl